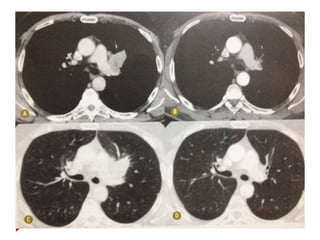

O documento discute os critérios RECIST (Response Evaluation Criteria in Solid Tumors) para avaliação de resposta ao tratamento em tumores sólidos através de imagens. O RECIST fornece diretrizes sobre como selecionar lesões alvo, realizar medidas, classificar respostas (completa, parcial, progressão ou estável) e limitações do método. Além disso, discute o uso de PET-TC e outros critérios para melhor avaliar determinados tipos de tumores.